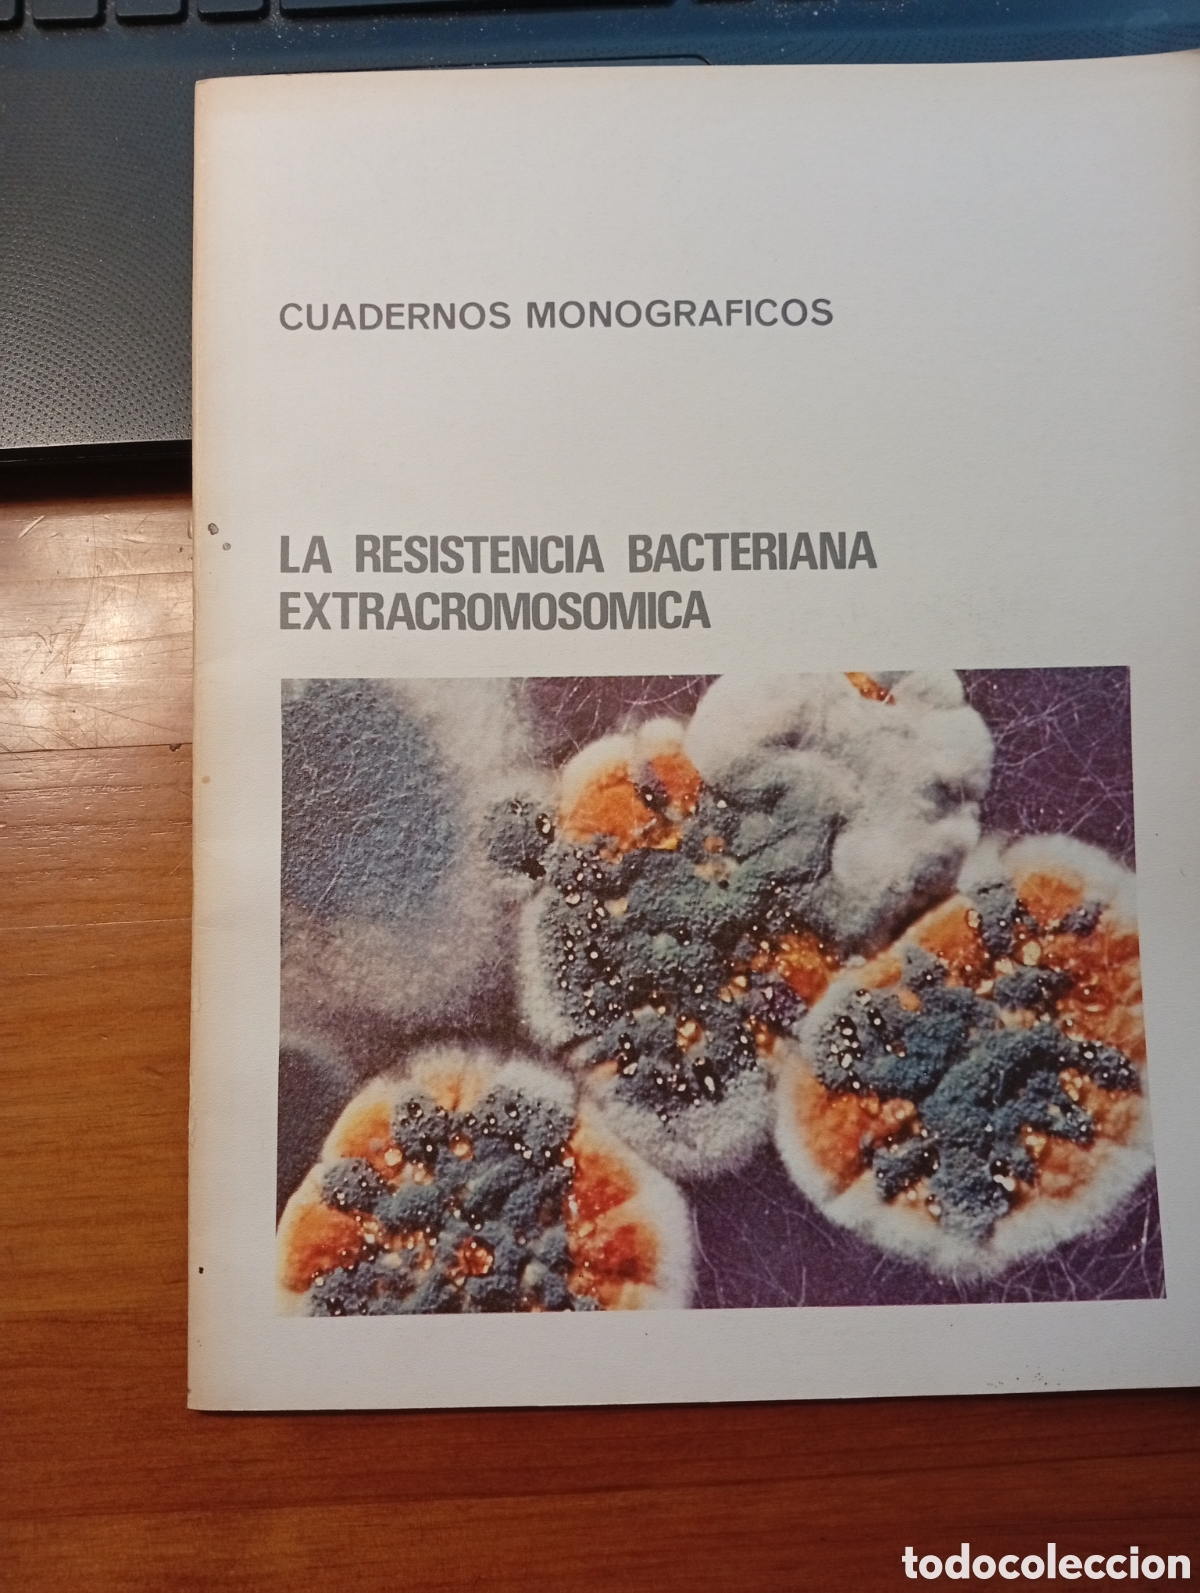
Libri di seconda mano: LA RESISTENCIA BACTERIANA EXTRACROMOSOMICA

74.670 lotti
Visualizzazione da
12961
a
12990
14,96 €
29,92 €
2,47 €
4,94 €

19,94 €
39,88 €

2,98 €
5,96 €
1,98 €
3,96 €

3,48 €
6,96 €
7,47 €
14,94 €
1,98 €
3,96 €
4,97 €
9,94 €
2,48 €
4,96 €
14,96 €
29,92 €
44,96 €
89,92 €
2,48 €
4,96 €

12,47 €
24,94 €
1,48 €
2,96 €
4,47 €
8,94 €

9,50 €
19,00 €

4,97 €
9,94 €
24,94 €
49,88 €
4,97 €
9,94 €
4,97 €
9,94 €
1,98 €
3,96 €

9,96 €
19,92 €
2,47 €
4,94 €
1,97 €
3,94 €
24,94 €
49,88 €
4,97 €
9,94 €
19,95 €
39,90 €

5,97 €
11,94 €

Español
Español
 English
English
 Deutsch
Deutsch
 Français
Français
 Português
Português
 Italiano
Italiano